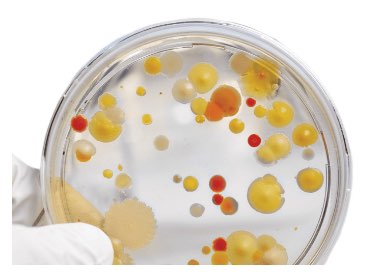
image of cleanroom testing

Data Center Downtime Defense: Hidden Contaminants, Crucial Interior Server Cleaning
After being asked to find the sources of downtime inside of thousands of critical environments it’s become clear that the primary threats are invisible to the naked eye. They are…

August 20, 2024 by The Expert
August 20, 2024 by The Expert 
